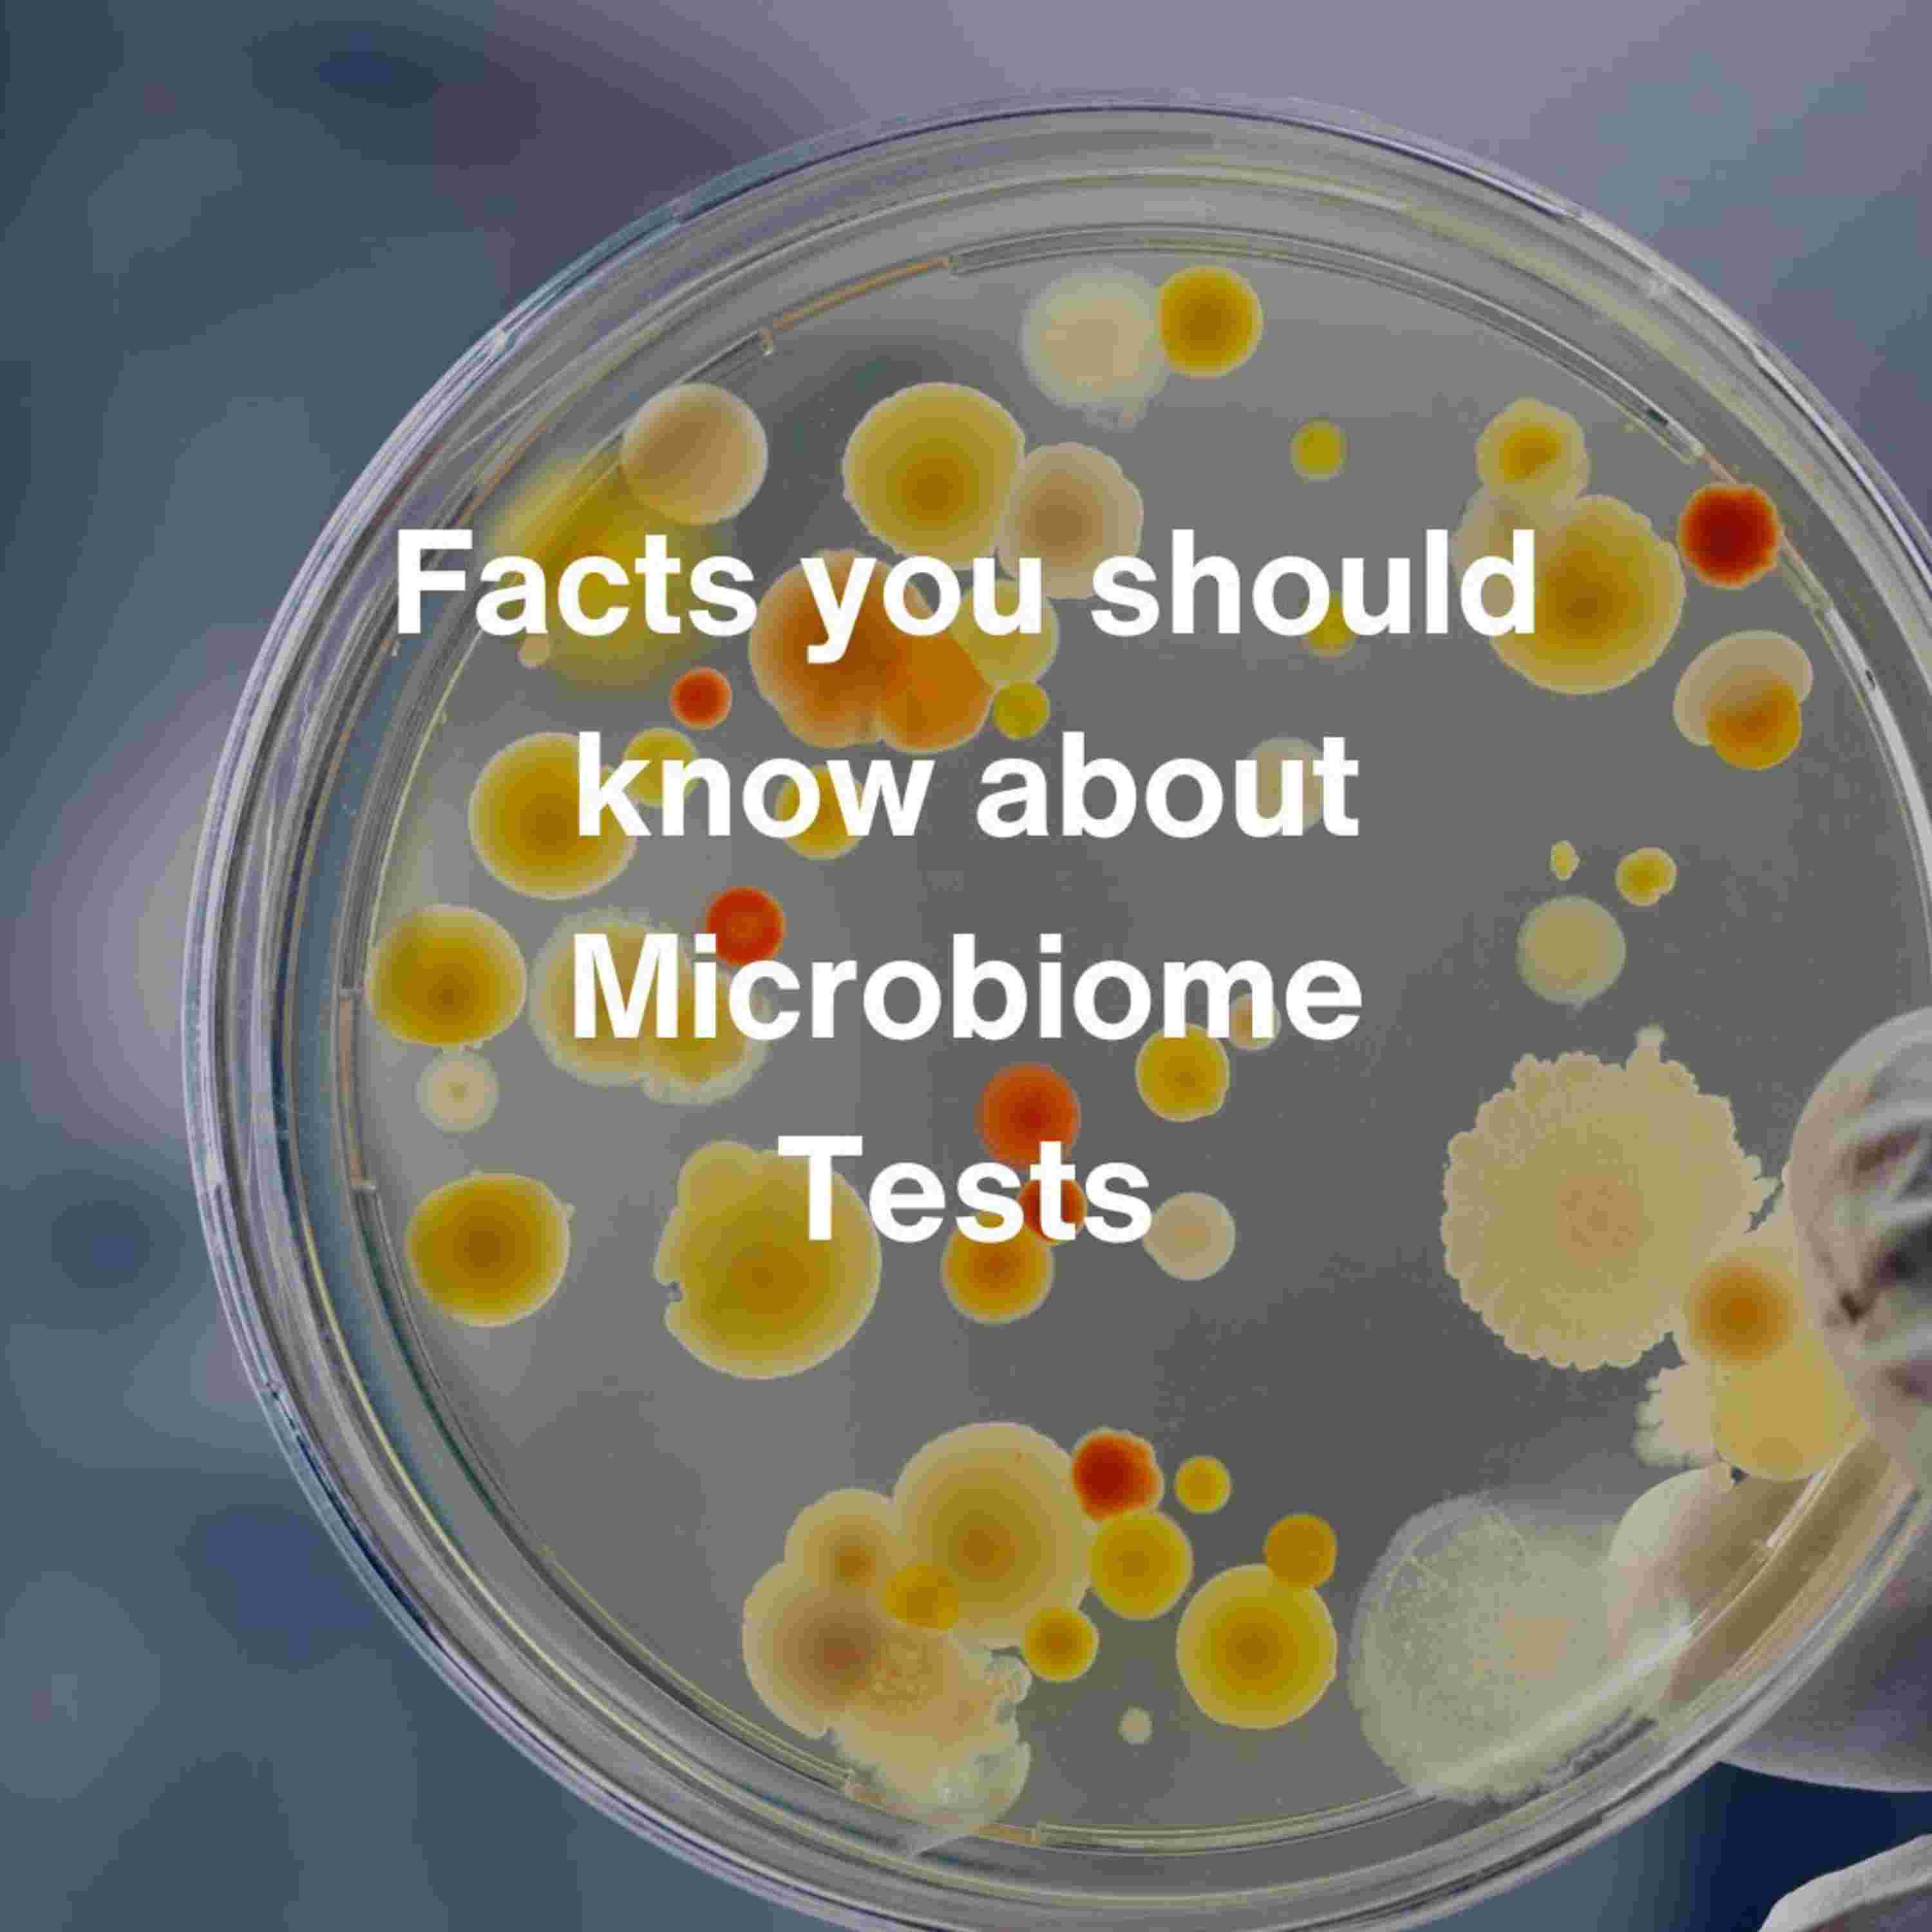
https://d3t3ozftmdmh3i.cloudfront.net/staging/podcast_uploaded_episode/6225008/6225008-1727347712654-ce11ee5eaab2a.jpg

Over the last 4-5 years, we have seen a flurry of gut microbiome DNA testing companies, claiming they have an out of box solution to reverse most chronic diseases! I am afraid this is far away from reality! No doubt, Gut microbiome has a vital role to play in overall physiology but these companies have less than optimal approach on two fronts -These companies do not focus on the system biology approach & fail to study other areas of microbiome including oral, skin, vaginal, scalp, immune system, mitochondria, hormonal health, heavy metals, toxins & more. -Driven by their investor/VC funds philosophy, these companies have adopted primitive DNA sequencing tech to make it an FMCG product/service rather than focussing on bringing scientific breakthroughs. These companies focusses on microbial composition & potential & fail to measure the biochemical functions at molecular level, thereby lacking precision, efficacy & accuracy. A complete departure from this linear outdated model, we at Genefitletics have adopted a system biology approach to -Offer system biology + mathematics platform - Measure the biochemical functions of gut & oral microbiome -Measure mitochondrial functions - collect, process & analyze molecular, longitudinal & clinical data to predict onset of various diseases including type 2 diabetes, cardiovascular diseases, chronic kidney disease & halitosis -Machine learnt models to predict glycemic response to 300 plus foods -Construct data driven precision nutrition & therapeutics interventions to rebalance an individuals’s biology -Collect longitudinal data at regular intervals to train our ML model, assess the efficacy of our interventions & revise the recommendations aligned with changes in individual’s biochemistry -now also offer oral cancer early detect test & associated disease prevention interventions Access to platform is now available for a monthly subscription model starting at Rs.2,500( $ 31) a month More details here: www.genefitletics.com #health #gutmicrobiome #gutmicrobiometest #guthealthtips #guthealthforlife #guthealth #typ2diabetes #obesity #thyroid #hashimoto #hypothyroidism #hypothyroidweightloss #hyperthyroidism #autoimmunedisease #autoimmuneawareness #autism #autismawarness #heartcondition #cardiovasculardisease #cardiovascularrisk #dnatesting #dnatest #dnadiet